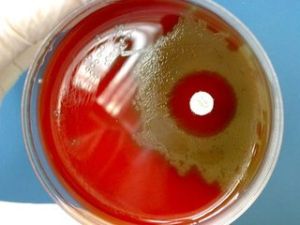
肺炎鏈球菌肺炎

疾病描述
 肺炎鏈球菌肺炎
肺炎鏈球菌肺炎疾病病因
 肺炎鏈球菌肺炎
肺炎鏈球菌肺炎症狀體徵
 肺炎鏈球菌肺炎
肺炎鏈球菌肺炎2.胸部體徵:早期只有輕度叩診濁音或呼吸音減弱。病程第2~3日肺實變後有典型叩診濁音、語顫增強及管性呼吸音等。消散期可聽到濕羅音。少數病例始終不見胸部異常體徵。確診須靠X線檢查。
3.X線檢查:早期可見肺紋理加深或限局於一個節段的淺薄陰影,以後有大片陰影均勻而緻密,占全肺葉或一個節段(圖24-8),經治療後逐漸消散。可見肺大泡。少數病例出現胸腔積液。值得指出,在肺部體徵出現之前,即可能用X線透視查出實變。多數患兒在起病3~4周后X線陰影消失。
4.自然病程:大多在病程第5~10日體溫驟退,可在24小時內下降4~5℃,低到35℃左右時,可見大汗及虛弱,類似休克狀態。早期套用抗生素治療者可於1~2日內退熱,肺部體徵約1周左右消失。
病理生理
肺炎鏈球菌肺炎
肺炎鏈球菌肺炎診斷檢查
診斷
 肺炎鏈球菌肺炎
肺炎鏈球菌肺炎實驗檢查
白細胞及中性粒細胞明顯增高,白細胞總數可達20×109/L以上,偶達50×109~70×109/L,但也有少數病兒的白細胞總數低下,常示病情嚴重。作氣道分泌物、血液、胸水培養可獲肺炎鏈球菌。此外,可採用從血、尿標本用CIE、LA等方法檢測肺炎鏈球菌莢膜抗原,用放射免疫、殺菌力試驗和ELISA等方法測定肺炎鏈球菌抗體作輔助診斷。尿檢查可見微量蛋白。C反應蛋白往往陽性。
治療措施
一般療法
 肺炎鏈球菌肺炎
肺炎鏈球菌肺炎西醫治療
(一)抗菌藥物治療
一經診斷即應給予抗菌藥物治療,不必等待細菌培養結果。首選青黴素G,用藥途徑及劑量視病情輕重及有無併發症而定:對於成年輕症患者,可用240萬U/d,分3次肌內注射,或用普魯卡因青黴素每12小時肌內注射6O萬U。病情稍重者,宜用青黴素G240萬-480萬U/d,分次靜脈滴注,每6-8小時1次;重症及並發腦膜炎者,可增至1000萬-3000萬U/d,分4次靜脈滴注。對青黴素過敏者,或耐青黴素或多重耐藥菌株感染者,可用呼吸氟喹諾酮類、頭孢噻肟或頭抱曲松等藥物,多重耐藥菌株感染者可用萬古黴素、替考拉寧等。
(二)支持療法
患者應臥床休息,注意補充足夠蛋白質、熱量及維生素。密切監測病情變化,注意防止休克。劇烈胸痛者,可酌用少量鎮痛藥,如可待因15mg。不用阿司匹林或其他解熱藥,以免過度出汗、脫水及干擾真實熱型,導致臨床判斷錯誤。鼓勵飲水每日1-2L,輕症患者不需常規靜脈輸液,確有失水者可輸液,保持尿比重在1.020。以下,血清鈉保持在145mmol/L以下。中等或重症患者(PaO2<60mmHg或有發紺)應給氧。若有明顯麻痹性腸梗阻或胃擴張,應暫時禁食、禁飲和胃腸減壓,直至腸蠕動恢復。煩躁不安、譫妄、失眠者酌用地西洋5mg或水合氯醛1-1.5g,禁用抑制呼吸的鎮靜藥。
(三)併發症的處理
經抗菌藥物治療後,高熱常在24小時內消退,或數日內逐漸下降。若體溫降而復升或3天后仍不降者,應考慮肺炎鏈球菌的肺外感染,如膿胸、心包炎或關節炎等。持續發熱的其他原因尚有耐青黴素的肺炎鏈球菌(PRSP)或混合細菌感染、藥物熱或並存其他疾病。腫瘤或異物阻塞支氣管時,經治療後肺炎雖可消散,但阻塞因素未除,肺炎可再次出現。約1O%-20%肺炎鏈球菌肺炎伴發胸腔積液者,應酌情取胸液檢查及培養以確定其性質。若治療不當,約5%並發膿胸,應積極排膿引流。
併發症狀
未經適當治療的病人可發生肺肉質變、機化性肺炎、急性漿液性纖維蛋白性胸膜炎,膿胸、關節炎、腦膜炎、心肌炎、化膿性心包炎等。敗血症病人可並發感染性休克、DIC。抗生素治療後併發症已少見。
疾病預防
 肺炎鏈球菌肺炎
肺炎鏈球菌肺炎疫苗作用我國使用的肺炎球菌疫苗為“多價肺炎球菌疫苗”(紐莫法23),美國默沙東公司研製生產,經我國衛生部批准在全國推行。
該疫苗是將肺炎球菌殺死,提取其莢膜多糖製成的,接種後誘發產生抗體,有效的預防肺炎球菌肺炎和敗血症。該疫苗包含了主要引起肺炎和敗血症的23種肺炎球菌,對90%的肺炎球菌產生免疫力,故稱“多價”。該疫苗經一次注射後,15天產生保護性抗體,保護期至少持續五年;必要時,在一次注射後第六年再注射一次。

